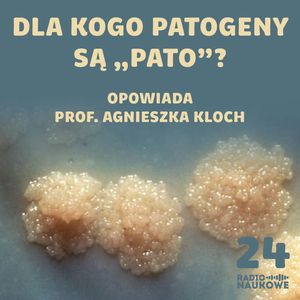
#24 Ewolucyjny wyścig zbrojeń. O potyczkach patogenów z ich ofiarami (w tym nami) | dr Agnieszka Kloch, Karolina Głowacka

Dlaczego wirusy przeskakują między gatunkami? Czy możemy to powstrzymać? Dlaczego patogeny są pato, czyli nie moglibyśmy wszyscy żyć w zgodzie? W Radiu Naukowym rozmawiamy o niekończącym się wyścigu zbrojeń między patogenami, a ich ofiarami. Jest o medycznych zastosowaniach nicieni, pochodzeniu wirusa HIV, a także o tym, czy może kiedyś przyjść zaraza, która zabije wszystkich ludzi. Opowiada dr Agnieszka Kloch z Wydziału Biologii Uniwersytetu Warszawskiego || https://patronite.pl/radionaukowe || https://radionaukowe.pl/
#24 Ewolucyjny wyścig zbrojeń. O potyczkach patogenów z ich ofiarami (w tym nami) | dr Agnieszka Kloch
- Głosy
- Długość
- 44 minuty
- Wydawca
- Format
- MP3
- Język
- Polski
Kolekcje, w których znajdziesz ten produkt:
Posłuchaj w całości
Dostępne w Klubie
W ramach subskrypcji Audioteka Klub
- Ponad 50.000 tytułów w ramach Klubu
- Nawet 500 nowości miesięcznie
- Blisko 700 audiobooków, których posłuchasz tylko w Audiotece
- Ponad 200 superprodukcji i audioseriali
Opis
Oceny i opinie słuchaczy
Tylko zalogowani użytkownicy mogą ocenić produkt. Zaloguj się
Opinie pochodzą od zarejestrowanych Klientów, którzy dokonali zakupu naszego produktu lub usługi. Opinie są zbierane, weryfikowane i publikowane zgodnie z Warunkami opiniowania.
Posłuchaj w całości
Dostępne w Klubie
W ramach subskrypcji Audioteka Klub
- Ponad 50.000 tytułów w ramach Klubu
- Nawet 500 nowości miesięcznie
- Blisko 700 audiobooków, których posłuchasz tylko w Audiotece
- Ponad 200 superprodukcji i audioseriali